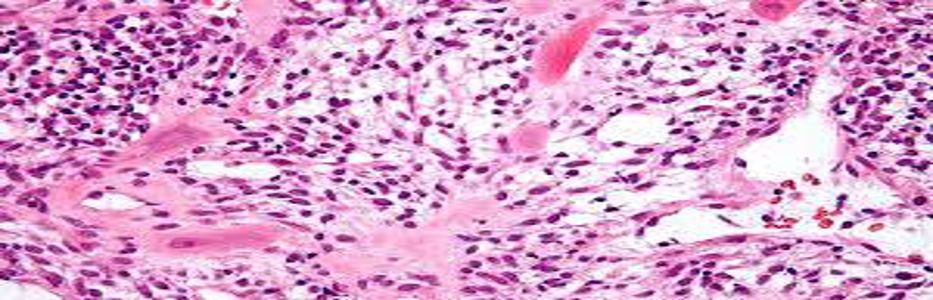

Placenta cells new hope for stroke victims

MELBOURNE: Giving stroke victims an injection of placenta cells could help heal the brain, according…
MELBOURNE: Giving stroke victims an injection of placenta cells could help heal the brain, according…